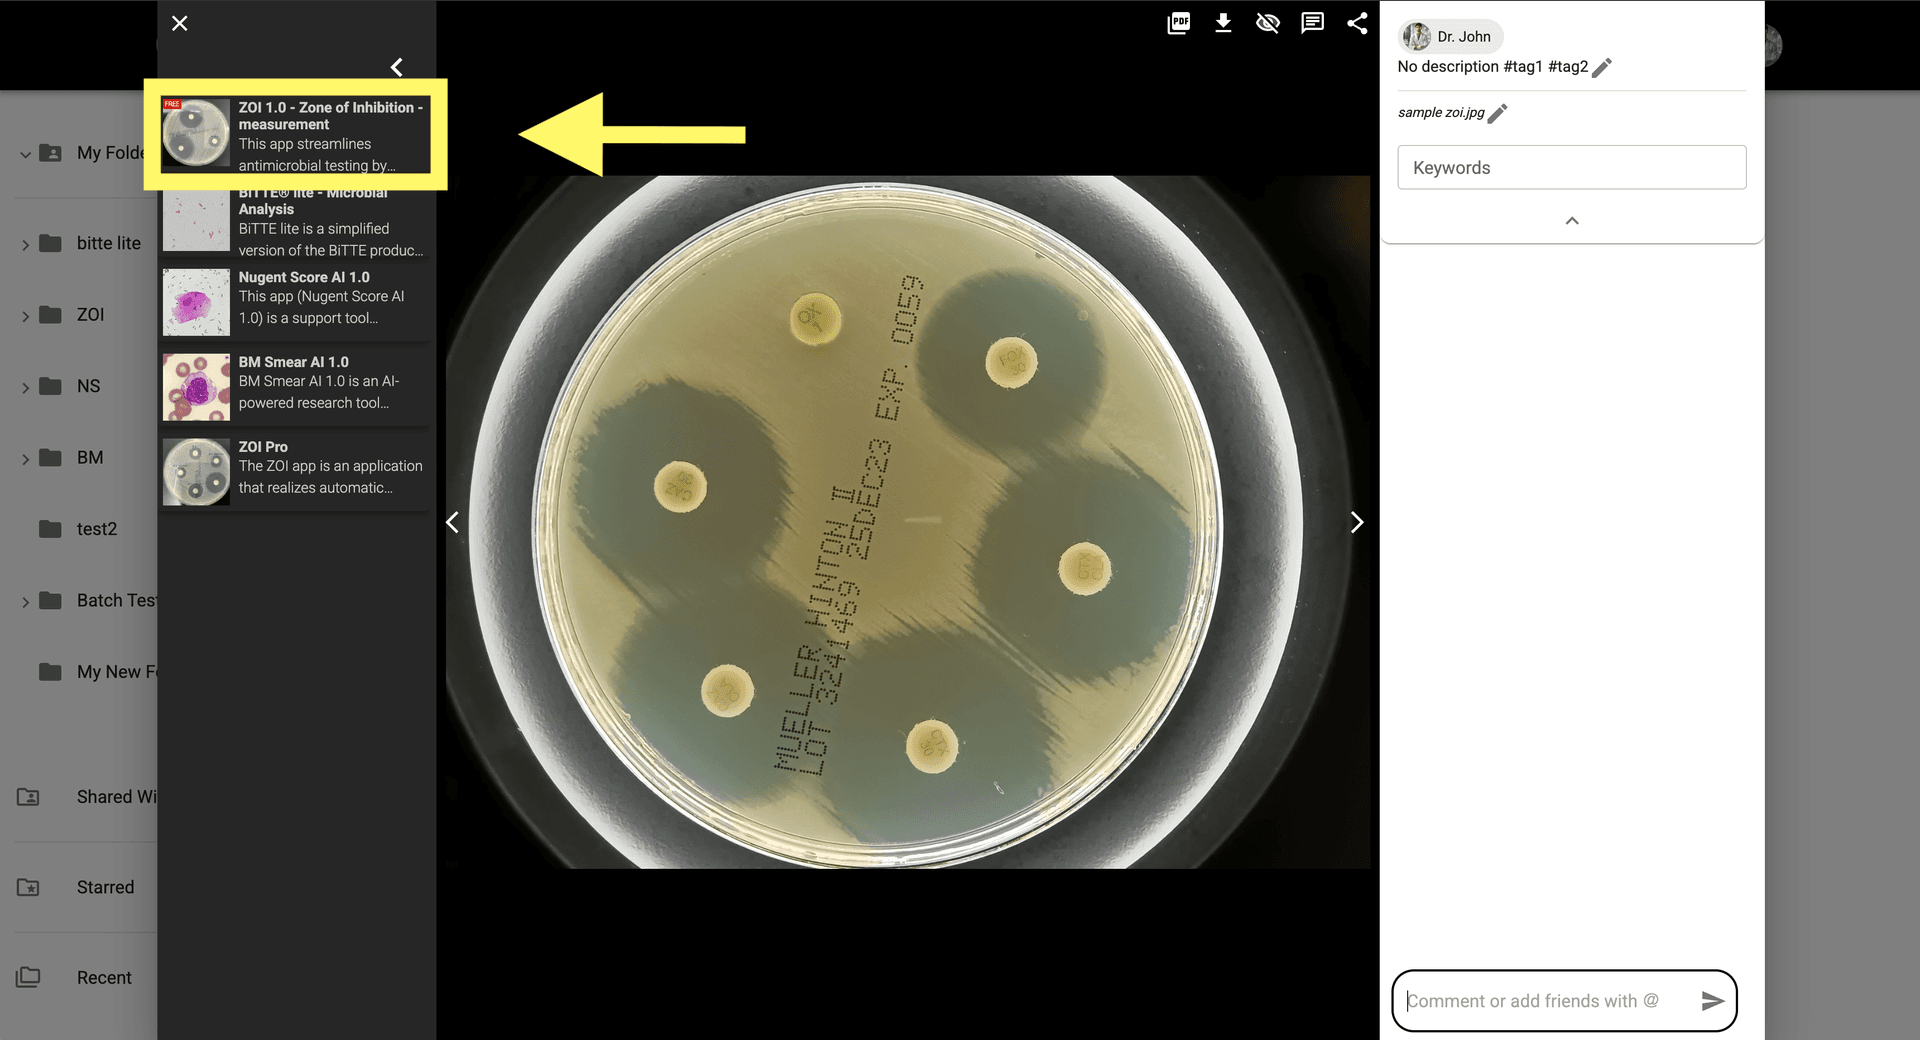
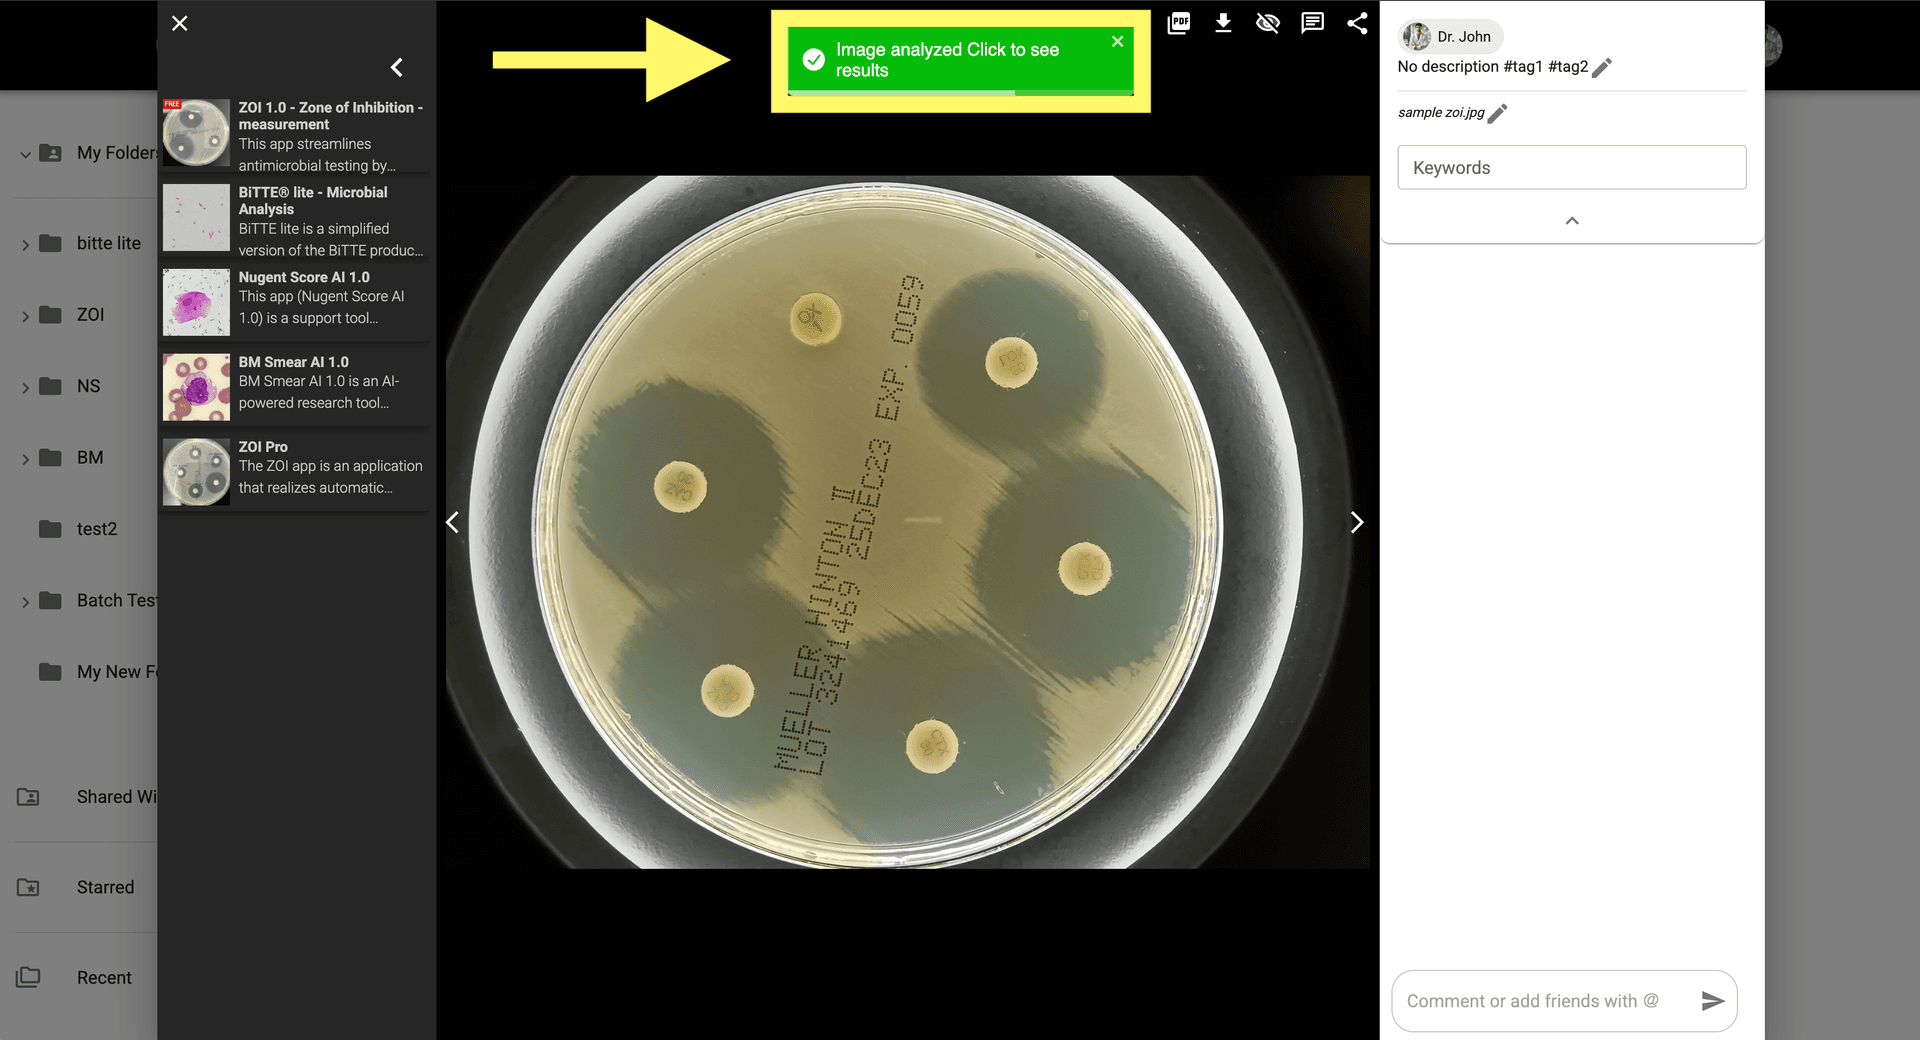
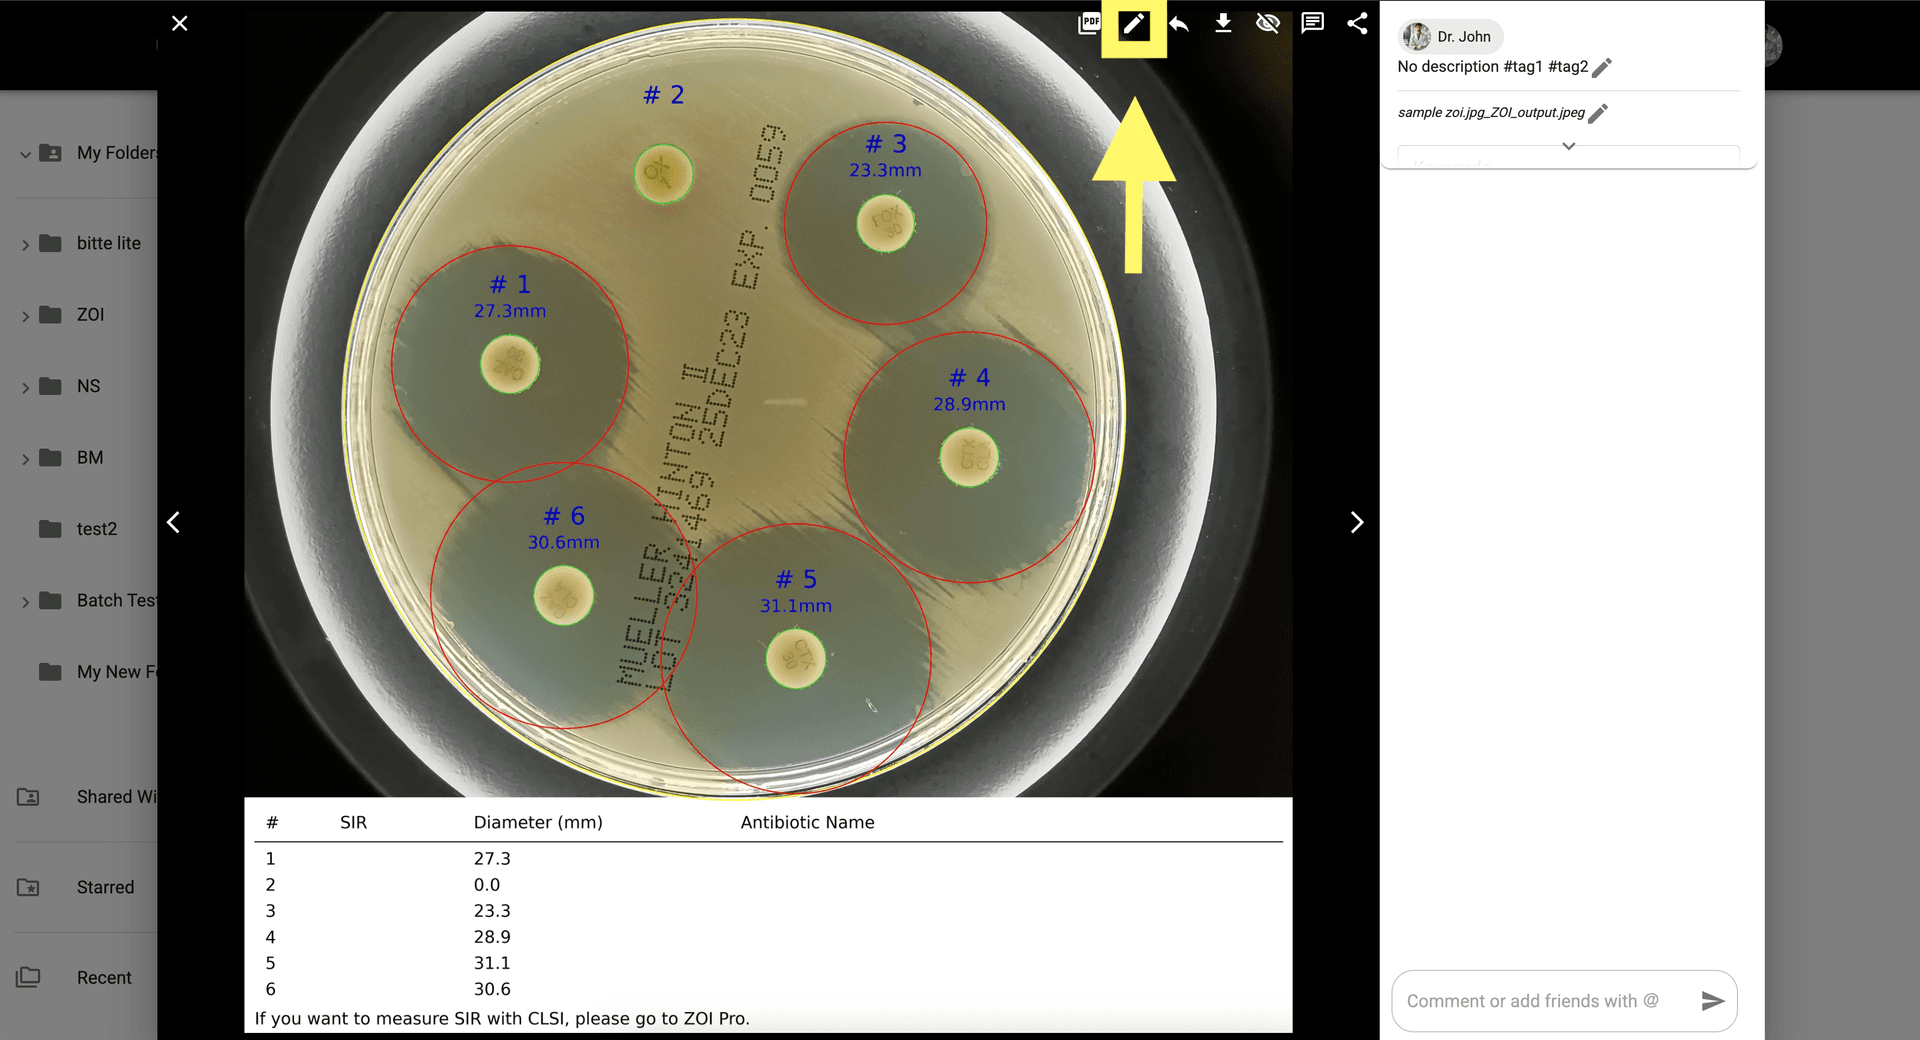

Comment utiliser ZOI 1.0 Zone de mesure d'inhibition
FR
Explorez l'application ZOI 1.0 Zone de mesure d'inhibition pour analyser des images et des ensembles de données avec des informations basées sur l'IA. Couramment utilisé dans un antibiogramme (diffusion sur agar, Kirby-Bauer) pour évaluer la sensibilité ou la résistance bactérienne lors du test de différents antibiotiques via des boîtes de Pétri et de l'agar Mueller-Hinton.
Depuis la galerie, cliquez sur une image ZOI pour l'ouvrir. Si vous n'avez pas d'images ZOI, vous pouvez en télécharger des exemples.ici
Cliquez sur l'icône ZOI 1.0 pour ouvrir les paramètres de l'application.
Configurez les paramètres d'analyse pour mesurer les zones d'inhibition et détecter l'inhibition de la croissance bactérienne.

Cliquez sur 'Analyser' pour lancer l'analyse et mesurer le ZOI par rapport à différents disques antibiotiques.

Consultez les résultats dans le modal d'image en cliquant sur la notification ou en ouvrant l'image générée depuis la galerie.
Pour ajuster les résultats manuellement, cliquez sur 'Afficher la correction AI' en haut à droite du modal d'image.
Activez les ajustements manuels pour affiner les zones ZOI si nécessaire.

Une fois terminé, cliquez sur 'Relancer l’analyse' pour enregistrer vos modifications manuelles et finaliser la mesure.

